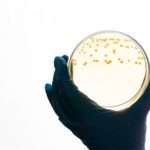
Симптоми і причини дисбактеріозу піхви

Блакитні лелеки, рожева коляска: як Меган Маркл плутає всіх зі статтю майбутньої дитини
Після того, як 37-річна Меган Маркл провела в Нью-Йорку традиційну американську вечірку з нагоди швидкого народження дитини – «бебі шауер», виникло припущення, що на світ зявиться дівчинка.
Гостра та хронічна фетоплацентарна недостатність
Зміст:Форми і ступеня тяжкості патологіїМожливі ризикиПричини, що провокують розвиток фетоплацентарної недостатностіСимптоматичні прояви патологіїДіагностикаЛікування фетоплацентарної недостатностіПоказання до оперативного втручанняПрофілактикаФетоплацентарна недостатність являє собою комплекс морфофункціональних порушень з боку плаценти і плода, що розвиваються на тлі різноманітних негативних чинників.
Красивий живіт: мама-медик розповіла про свій досвід позбавлення від розтяжок на шкірі
Вагітність – прекрасний час, якби не різні «але». Це токсикоз, зайва вага, набряки, розтяжки... Ось про них і поговоримо.Малюк, що росте під серцем майбутньої мами, впливає на те, як змінюється стан її шкіри.
Як підріс: Олександр Яценко показав молодшого сина
41-річний Олександр Яценко, відомий за фільмом «Аритмія» і серіалом «Негода», 10 жовтня минулого року став батьком вдруге. Його кохана Ксенія народила сина, якого пара вирішила назвати Арсенієм.
Яніна Студилина розповіла про 17-годинних пологи в Америці і маленькій дочці
33-річна Яніна Студилина — не тільки талановита і затребувана актриса, але і щаслива дружина Олександра Роднянського-молодшого і мама чарівної Ганнусі, якому в грудні виповниться 3 роки.
Жіночність і завзяття: Ірина Безрукова і Оксана Федорова зробили зачіски-близнюки
На цьому тижні в столиці пройшло безліч гучних світських заходів і стала літня погода підштовхнула багатьох знаменитостей на експерименти із зовнішністю, зокрема з зачісками.Читайте також:Битва зачісок: хто з зірок більше здивував зміною іміджу?Наприклад, 54-річна Ірина Безрукова зявилася на офіційному закриття 41-го Московського кінофестивалю в оригінальному плаття шоколадно-кавового відтінку від російського модельєра Олени Ахмадуліної з оголеним плечем і вишивкою у вигляді лисиці на ліфі.© Instagram @irina_bezrukova_officialЧисленні шанувальники відзначили, що неймовірне плаття відтіняє білизну її шкіри, а романтична укладання з красивими локонами, які обрамляють обличчя, їй неймовірно йде.А раніше, Ірина, також в рамках ММКФ відвідала італійську вечірку журналу Hello і приємно здивувала присутніх гостей і шанувальників стильним шкіряним піджаком і сукнею від Шанель.
Анастасія Цвєтаєва назвала 4 причини, за якими вона вибрала кесарів розтин
37-річна актриса Анастасія Цвєтаєва незабаром стане мамою втретє. До зустрічі з малюком залишилися лічені тижні. В очікуванні пологів Цвєтаєва поділилася зі своїми читачами свого мікроблога спогадами про колишні пологах.
Зміцнення волосся в домашніх умовах
Зміст:Чому рідшають пасмаМаски для росту волоссяЗміцнення волосся касторовою олієюБагатокомпонентна маска з репяховою масломМаска для росту волосся з маслом розмариновимРегулярні стреси, гормональні збої, сушіння та фарбування негативно позначаються на стані локонів.
Свято в деталях: як створити атмосферу нового року на кухні
Як без зайвих зусиль створити святковий настрій? разом з експертами компанії "хаят росія", що випускає високоякісні паперово-гігієнічні продукти, ми підготували незвичайні поради, які допоможуть...
Симптоми і причини дисбактеріозу піхви
Зміст:Нормальні показники мікрофлори піхвиЩо це за патологія?Причини розвитку дисбіозуСимптоми хронічного вагінозуДіагностикаТерапія хронічного дисбіозу у жінокНародні засоби при вагінозі після антибіотиківПрофілактикаПриємне відчуття чистоти і свіжості в інтимній зоні – що може бути краще? Але іноді дівчата спостерігають печіння і неприємний запах з піхви.
Що таке синдром дефіциту уваги у дітей
Зміст:Що таке синдром дефіциту уваги у дітейЯкі причини СДУГСимптоми синдрому гіперактивностіКорекція поведінкиФармакотерапія при синдромі дефіциту уваги у дітейЛікування за допомогою психологічної терапіїПравильне харчуванняВітамінотерапіяСоціальна підтримкаСиндром дефіциту уваги і гіперактивності викликає серйозні проблеми у дитини.
Несподіваний погляд Косто на крем-брюле
Забудьте все, що ви думали про крем-брюле. Найновіша пропозиція пекарні Costco натхненна класичним французьким десертом, але перетворює його на абсолютно...
Эхо Разочарования: Дженнифер Лопес Готовится к “Отмщению” в Новом Альбоме о Бене Аффлеке
Свежий ветер скандала подул с берегов Голливуда, неся на себе слухи о грядущем музыкальном откровении Дженнифер Лопес. Ее новый альбом, словно исповедь, предвещает быть...
Для маленьких мандрівників: 40 яскравих дитячих валіз
Діти — залучені учасники зборів в подорож. Здається, вони присутні відразу всюди: контролюють комплектацію аптечки, допомагають складати мамині сукні, приміряють татусеві шорти (а може, вже саме?!) і намагаються додати у валізу все нові і нові іграшки...
Рідкісний кадр: Ксенія Лаврова-Глінка показала всіх своїх дітей
41-річна Ксенія Лаврова-Глінка не тільки успішна актриса, але і щаслива мама трьох дітей. Старшому синові Данилу 18 років, доньці Аглае 12 років, а самого молодшого Миколи артистка народила в жовтні 2017 року.
Голос правди: топ-5 книг джона бойна, які слід прочитати
З чим у вас асоціюється дублін? велосипедні прогулянки? жива музика? трініті-коледж? або відразу ж на думку приходять відомі імена: джеймс джойс, брем стокер, бернард...
Мегауретер у дітей до року: що може сучасна хірургія
Зміст:Види та класифікаціяСимптомиЛікуванняОпераціяМегауретер, мегалоуретер, мегадолихоуретер, уретерогидронефроз, гидроуретер – все це назви однієї і тієї ж вродженої патології, при якій сечовід патологічно розширюється.
Що робити, якщо дитина часто кліпає очима?
Зміст:Чому дитина часто кліпає очимаПсихологічні фактори, що викликають часте морганняЩо робити для лікуванняРекомендації для батьків, дитина яких часто кліпає очимаМоргання являє собою рефлекторну дію, необхідне для того, щоб запобігти пересихання слизової оболонки ока, а також усунути сторонні частинки.
Поки тата немає вдома: Алла Пугачова влаштувала дітям катання по річці
Пятирічний Гаррі Галкін росте справжнім чоловіком. Поки його знаменитий тато на гастролях в Ізраїлі, хлопчик бере на себе його обовязки і забезпечує дозвілля та безпеку родини.
Поважні причини не мати заробітку для допомоги від 3 до 7 років, від 8...
Поважні причини відсутності доходу. Коли без офіційного заробітку допомогу призначать. Чому можуть відмовити багатодітним і батькові з дитиною у віці до 3 років. Дивіться...